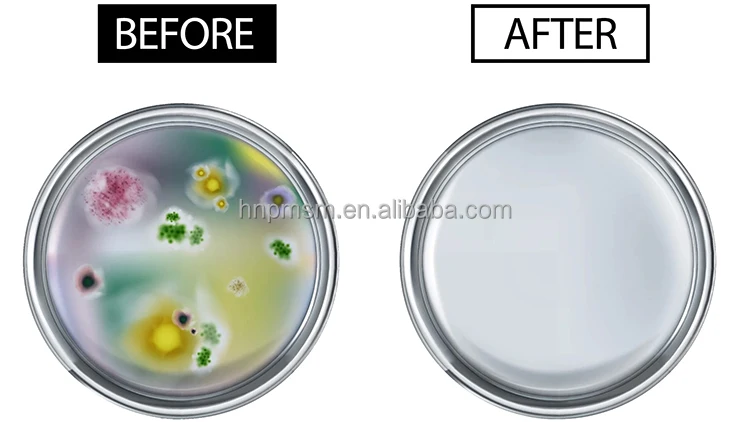

Top High Efficiency Sterilization Equipment Popular High Capacity Sterilization Device Nail Salon Autoclave Sterilizer
- Category: >>>
- Supplier: Zhengzhou Bingrong Information Technology Co. Ltd.Zhengzhou Ltd.
Share on (1601204785448):
Product Overview
Description
Top High-Efficiency Sterilization Equipment Popular High-Capacity Sterilization Device Nail Salon Autoclave Sterilizer


Use:
This vertical sterilizer is a safe, reliable, and automatically controlled sterilization equipment. It consists of a heating system, microcomputer control system, and overheating and overpressure protection system. The unit is characterized by its reliable disinfection and sterilization effects, ease of operation, safety in use, energy efficiency, durability, and cost-effectiveness. It is an ideal device for medical, health, and research institutions to disinfect and sterilize surgical instruments, dressings, utensils, culture media, etc.
Performance and Characteristics:
High-quality stainless steel material: Made of high-quality stainless steel, the sterilizer has excellent corrosion resistance and durability.
Audible alert and automatic shutdown upon sterilization completion: It emits a beep and automatically shuts down when sterilization is complete, ensuring timely attention.
Digital display of working status, touch-sensitive buttons: Equipped with a digital display screen to visually indicate the working status, operated via touch-sensitive buttons for convenient control.
Simple operation, safe and reliable: Easy to operate with a focus on safety and reliability, ensuring effective sterilization processes.
Automatic discharge of cold air and steam at the end of sterilization: Automatically releases cold air and steam after sterilization to safely release internal pressure.
Equipped with double-layer stainless steel mesh basket: Includes a double-layer stainless steel mesh basket for easy loading and cleaning, enhancing sterilization effectiveness and efficiency.
Model technical data | BR-35LD | BR-50LD | BR-75LD | BR-100LD | BR-120LD | BR-150LD |
Chamber volume | 35L/9 gal | 50L/13 gal | 75L/20 gal | 100L/26 gal | 120L/32 gal | 150L/40 gal |
(φ318×450mm) | (φ340×550mm) | (φ400×600mm) | (φ440×650mm) | (φ480×660mm) | (φ510×740mm) | |
(φ13*18inch) | (φ13*22inch) | (φ16*24inch) | (φ17*26inch) | (φ19*26inch) | (φ20*29inch) | |
Working temperature | 134℃ / 209°F | |||||
Max working pressure | 0.25 Mpa | |||||
Heat average | ≤±1℃ | |||||
Timer | 0~99min or 0~99hour59min | |||||
Adjustment of temperature | 105~134℃ | |||||
Power | 2.5Kw | 3Kw | 4.5KW | 6KW | ||
Overall dimension | 470×450×840(mm) | 520×500×970(mm) | 550×530×990(mm) | 580×560×1060(mm) | 630×610×1130(mm) | 660×640×1130(mm) |
19*18*33 inch | 20*20*38inch | 22*21*39 inch | 23*22*42 inch | 25*24*44 inch | 26*25*44 inch | |
Transport dimension | 540×540×990(mm) | 580×580×1030(mm) | 610×610×1160(mm) | 640×640×1220(mm) | 690×690×1290(mm) | 730×730×1290(mm) |
21*21*39 inch | 23*23*44 inch | 24*24*45 inch | 25*25*48 inch | 27*27*50 inch | 29*29*50 inch | |
G.W/N.W | 64Kg/ 47Kg | 77Kg/56Kg | 90Kg/70Kg | 98Kg/76Kg | 125Kg/ 103Kg | 138Kg/111Kg |
141 lbs/103 lbs | 169 lbs/123 lbs | 198 lbs/154 lbs | 216 lbs/167 lbs | 275 lbs/227 lbs | 304 lbs/244 lbs | |
| Machine Display | |
 |  |
 |  |
| Detailed Display | |
 | |
| Sterilization Effectiveness | |
| |
| Wide Range of Applications | |
 | |
| Additional Models | |
 | |

1. Lead time
About 1 to 5 days for spot goods and 14 days for customized items, also depending on quantity.
2. Package
(1) Pack all goods according to customers' requirements, like putting item bar code, FBA label, and so on.
(2) Standard export carton (can be wrapped with non-woven bag)
3. Delivery
(1) By courier, air, sea, railway or land. If necessary, DDP can be handled.
(2) Shipping method is affordable and stable. We have advantageous logistics to USA, Canada, European coutries, Southeast Asia and
some African countries. Best shipping way will be suggested according to final gross weight and volume.
(3) Global DDP logistics service to FBA warehouse can be provided.
We Recommend
Autoclave for Glass Bottle Food Sterilizers Household Sterile Pouch Machines
Horizontal 35L 50L 75L 100L 120L 150L Automatic Steam Sterilization Machine
INCHOI Automatic Steam and Air Retort/Autoclave Sterilization Machine
New Arrivals
New products from manufacturers at wholesale prices





















